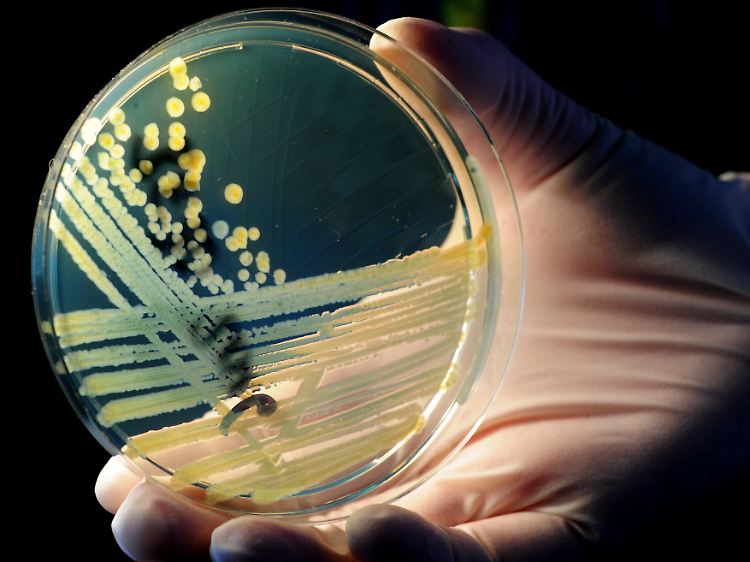

Einsatz von Antibiotika verringern Abwehrstoffe verstärken Wirkung
27.04.2012, 13:26 UhrSchon lange sind Forscher in Sorge, da das häufig vorschnelle Verschreiben von Antibiotika die Erreger gegen das Medikament resistent machen. Jetzt gibt ein Experiment Anlass zur Hoffnung, dass der Einsatz von Antibiotika reduziert werden kann.
Eine Kombination aus körpereigenen Stoffen und Antibiotika soll E.coli-Keime besser bekämpfen.
(Foto: picture alliance / dpa)
Die körpereigene Abwehr gegen Infektionen kann die Wirkung von Antibiotika verstärken - zumindest bei Mäusen. Das berichten US-amerikanische Forscher in der Fachzeitschrift "Nature". Bestimmte Stoffe, die an der Regulation der Immunabwehr beteiligt sind könnten so vielleicht helfen, den Einsatz von Antibiotika zu verringern.
Die Abwehr des Körpers gegen Infektionen ist ein sehr komplizierter, noch immer nicht vollständig verstandener Prozess. Unter anderem sind daran sogenannte Entzündungs-auflösende Faktoren ("Specialized pro-resolving mediators" oder kurz SPM) beteiligt. Diese Stoffe könnten eine größere Rolle spielen als bisher angenommen, schreibt Charles Serhan von der Harvard Medical School in Boston (USA).
Antibiotika effizienter einsetzen
Serhan und seine Mitarbeiter identifizierten SPMs mit der Bezeichnung Resolvin D1 und D5 sowie Protectin D1, die die Wirkung von Antibiotika zu verstärken scheinen. Die Forscher infizierten Mäuse mit einem Stamm der Darmbakterien E.coli und gaben ihnen zusätzlich entweder kleine Dosen ihrer eigenen SPMs, übliche Antibiotika oder eine Kombination aus beidem.
Dabei fanden sie, dass die Kombination der SPMs mit Antibiotika die Bakterien besser zurückdrängte sowie die Infektion und Entzündungen schneller zurückgehen ließ als jede Maßnahme allein. Außerdem wirkte eine Kombination beider Faktoren auch besser gegen das Bakterium Staphylococcus aureus, der gefürchteten Ursache der meisten tödlichen Krankenhausinfektionen.
Die Kombinationswirkung könne einen Weg zeigen, Antibiotika effizienter und in kleineren Dosen einzusetzen, hoffen die Forscher. Weltweit steigt die Sorge, dass die Antibiotika wegen zunehmender Resistenzen der Erreger immer weniger wirken und schon als beherrschbar geglaubte Infektionen wieder zunehmen.
Quelle: ntv.de, dpa